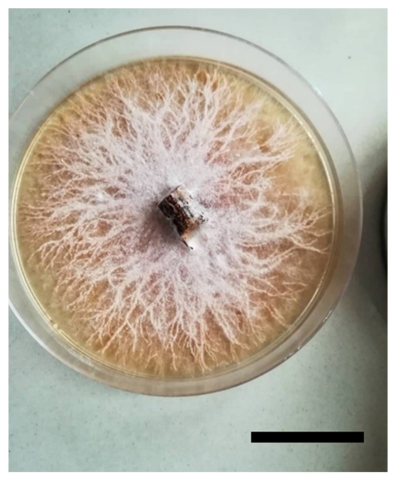
Ijpb 16 00020 g004

Indigenous Arbuscular Mycorrhizal Fungi Consortium Enhances Growth and Protects Boufeggous Gharas Date Palm Against Fusarium oxysporum f. sp. albedinis Infection in Figuig Oasis (Morocco)
Abstract
1. Introduction
2. Materials and Methods
2.1. Plant Materials and Experimental Design
2.2. Isolation of AMF and Inoculation of Date Palm Seedlings
2.3. Foa Isolation and Infection of Date Palm Seedlings
2.4. Date Palm Seedling Inoculation with Both AMF and Foa
2.5. Evaluation of AMF Colonization
2.6. Foa Isolation from Infected Seedlings
2.7. Assessment of Plant Growth Parameters
2.8. Statistical Analyses
3. Results
3.1. Morphological Characterization of AMF Spores from the Consortium Isolated in the Figuig Oasis
3.2. Foa Isolation from Infected Boufeggous Gharas Rachis
3.3. Mycorrhization Improves Growth Parameter of Date Palm Seedlings
3.4. Mycorrhization Mitigates the Impact of Foa on Date Palm Growth
4. Discussion and Concluding Remarks
Author Contributions
Funding
Data Availability Statement
Acknowledgments
Conflicts of Interest
References
- Benmeddour, Z.; Mehinagic, E.; Le Meurlay, D.; Louaileche, H. Phenolic Composition and Antioxidant Capacities of Ten Algerian Date (Phoenix dactylifera L.) Cultivars: A Comparative Study. J. Funct. Foods 2013, 5, 346–354. [Google Scholar] [CrossRef]
- Oihabi, A. Date Palm in North Africa: Trumps and Problems. In Proceedings of the Second International Conference on Date Palms, Al-Ain, United Arab Emirates, 25–27 March 2001; pp. 25–27. [Google Scholar]
- Meddich, A.; Jaiti, F.; Bourzik, W.; El Asli, A.; Hafidi, M. Use of Mycorrhizal Fungi as a Strategy for Improving the Drought Tolerance in Date Palm (Phoenix dactylifera). Sci. Hortic. 2015, 192, 468–474. [Google Scholar] [CrossRef]
- Djerbi, M. Diseases of the Date palm: Present Status and Future Prospects. J. Agric. Mar. Sci. [JAMS] 1998, 3, 103–114. [Google Scholar] [CrossRef]
- Daayf, F.; El Bellaj, M.; El Hassni, M.; J’aiti, F.; El Hadrami, I. Elicitation of Soluble Phenolics in Date Palm (Phoenix dactylifera) Callus by Fusarium oxysporum f. sp. albedinis Culture Medium. Environ. Exp. Bot. 2003, 49, 41–47. [Google Scholar] [CrossRef]
- Abdelilah, M.; Ali, B. First Detection of Potosia Opaca Larva Attacks on Phoenix dactylifera and Phoenix canariensis in Morocco: Focus on Pests Control Strategies and Soil Quality of Prospected Palm Groves. J. Entomol. Zool. Stud. 2017, 5, 984–991. [Google Scholar]
- Ministère de l’Agriculture, de la Pêche Maritime, du Développement Rural et des Eaux et Forêts Les Ksour de Figuig: Cultures Oasiennes et Pastorales Autour de La Gestion Sociale de l’eau et Des Terres:: Dossier d’inscription Du Site Figuig Comme Système Ingénieux Du Patrimoine Agricole Mondial (SIPAM); Organisation des Nations Unies pour l’Alimentation et l’Agriculture (FAO): Rome, Italy, 2021.
- Al-Karaki, G.N. Growth of Mycorrhizal Tomato and Mineral Acquisition under Salt Stress. Mycorrhiza 2000, 10, 51–54. [Google Scholar] [CrossRef]
- Redecker, D.; Morton, J.B.; Bruns, T.D. Ancestral Lineages of Arbuscular Mycorrhizal Fungi (Glomales). Mol. Phylogenet. Evol. 2000, 14, 276–284. [Google Scholar] [CrossRef]
- Smith, S.E.; Read, D.J. Mycorrhizal Symbiosis; Academic Press: Cambridge, MA, USA, 2010; ISBN 0-08-055934-4. [Google Scholar]
- Janos, D.P. Plant Responsiveness to Mycorrhizas Differs from Dependence upon Mycorrhizas. Mycorrhiza 2007, 17, 75–91. [Google Scholar] [CrossRef]
- Azcón-Aguilar, C.; Barea, J. Arbuscular Mycorrhizas and Biological Control of Soil-Borne Plant Pathogens–an Overview of the Mechanisms Involved. Mycorrhiza 1997, 6, 457–464. [Google Scholar] [CrossRef]
- Pozo, M.J.; Azcón-Aguilar, C. Unraveling Mycorrhiza-Induced Resistance. Curr. Opin. Plant Biol. 2007, 10, 393–398. [Google Scholar] [CrossRef]
- Oihabi, A. Effet Des Endomycorhizes VA Sur La Croissance et La Nutrition Minérale Du Palmier Dattier. Ph.D. Thesis, Université Cadi Ayyad de Marrakech, Maroc/Univ. Bourgogne, Dijon, France, 1991; p. 117. [Google Scholar]
- Gagou, E.; Chakroune, K.; Abbas, M.; Lamkami, T.; Hakkou, A. Evaluation of the Mycorrhizal Potential of Date Palm (Phoenix dactylifera L.) Rhizosphere Soils in the Figuig Oasis (Southeastern Morocco). J. Fungi 2023, 9, 931. [Google Scholar] [CrossRef] [PubMed]
- Gerdemann, J.W.; Nicolson, T.H. Spores of Mycorrhizal Endogone Species Extracted from Soil by Wet Sieving and Decanting. Trans. Br. Mycol. Soc. 1963, 46, 235–244. [Google Scholar] [CrossRef]
- Brundrett, M. Practical Methods in Mycorrhiza Research: Based on a Workshop Organized in Conjunction with the Ninth North American Conference on Mycorrhizae; University of Guelph: Guelph, ON, Canada, 1994. [Google Scholar]
- Dickson, S.; Smith, S.; Smith, F. Characterization of Two Arbuscular Mycorrhizal Fungi in Symbiosis with Allium porrum: Inflow and Flux of Phosphate across the Symbiotic Interface. New Phytol. 1999, 144, 173–181. [Google Scholar] [CrossRef]
- Souna, F.; Chafi, A.; Chakroune, K.; Himri, I.; Bouakka, M.; Hakkou, A. Effect of Mycorhization and Compost on the Growth and the Protection of Date Palm (Phoenix dactylifera L.) against Bayoud Disease. Am.-Eurasian J. Sustain. Agric. 2010, 4, 260–267. [Google Scholar]
- Locke, T.; Colhoun, J. Contributions to a Method of Testing Oil Palm Seedlings for Resistance to Fusarium oxysporum Schl. f. sp. elaeidis Toovey. Phytopathol. Z. 1974, 79, 77–92. [Google Scholar] [CrossRef]
- Koske, R.E.; Gemma, J.N. A Modified Procedure for Staining Roots to Detect VA Mycorrhizas. Mycol. Res. 1989, 92, 486–488. [Google Scholar] [CrossRef]
- Trouvelot, A. Measure Du Taux de Mycorrhization d’un Systeme Radiculaire. Recherche de Methods d’estimation Ayant Une Signification Fonctionnelle. Physiol. Genet. Asp. Mycorrhizae 1986, 217–221. [Google Scholar]
- Meddich, A.; Ait El Mokhtar, M.; Bourzik, W.; Mitsui, T.; Baslam, M.; Hafidi, M. Optimizing Growth and Tolerance of Date Palm (Phoenix dactylifera L.) to Drought, Salinity, and Vascular Fusarium-Induced Wilt (Fusarium oxysporum) by Application of Arbuscular Mycorrhizal Fungi (AMF). Root Biol. 2018, 52, 239–258. [Google Scholar]
- Jaiti, F.; Meddich, A.; El Hadrami, I. Effectiveness of Arbuscular Mycorrhizal Fungi in the Protection of Date Palm (Phoenix dactylifera L.) against Bayoud Disease. Physiol. Mol. Plant Pathol. 2007, 71, 166–173. [Google Scholar] [CrossRef]
- Caravaca, F.; Barea, J.; Palenzuela, J.; Figueroa, D.; Alguacil, M.; Roldán, A. Establishment of Shrub Species in a Degraded Semiarid Site after Inoculation with Native or Allochthonous Arbuscular Mycorrhizal Fungi. Appl. Soil Ecol. 2003, 22, 103–111. [Google Scholar] [CrossRef]
- Antunes, P.M.; Koch, A.M.; Morton, J.B.; Rillig, M.C.; Klironomos, J.N. Evidence for Functional Divergence in Arbuscular Mycorrhizal Fungi from Contrasting Climatic Origins. New Phytol. 2011, 189, 507–514. [Google Scholar] [CrossRef] [PubMed]
- Elsen, A.; Gervacio, D.; Swennen, R.; De Waele, D. AMF-Induced Biocontrol against Plant Parasitic Nematodes in Musa sp.: A Systemic Effect. Mycorrhiza 2008, 18, 251–256. [Google Scholar] [CrossRef] [PubMed]
- Caron, M.; Fortin, J.; Richard, C. Effect of Inoculation Sequence on the Interaction between Glomus intraradices and Fusarium oxysporum f. sp. radicis-lycopersici in Tomatoes. Can. J. Plant Pathol. 1986, 8, 12–16. [Google Scholar] [CrossRef]
- Bärtschi, H.; Gianinazzi-Pearson, V.; Vegh, I. Vesicular-Arbuscular Mycorrhiza Formation and Root Rot Disease (Phytophthora cinnamomi) Development in Chamaecyparis Lawsoniana. Phytopathol. Z. 1981, 102, 213–218. [Google Scholar] [CrossRef]
- Harrison, M.J. The Arbuscular Mycorrhizal Symbiosis. In Plant-Microbe Interactions; Springer: Berlin/Heidelberg, Germany, 1997; pp. 1–34. [Google Scholar]
- Morandi, D. Occurrence of Phytoalexins and Phenolic Compounds in Endomycorrhizal Interactions, and Their Potential Role in Biological Control. Plant Soil 1996, 185, 241–251. [Google Scholar] [CrossRef]
- Ismail, Y.; McCormick, S.; Hijri, M. The Arbuscular Mycorrhizal Fungus, Glomus irregulare, Controls the Mycotoxin Production of Fusarium sambucinum in the Pathogenesis of Potato. FEMS Microbiol. Lett. 2013, 348, 46–51. [Google Scholar] [CrossRef]
- Ismail, Y.; Hijri, M. Arbuscular Mycorrhisation with Glomus irregulare Induces Expression of Potato PR Homologues Genes in Response to Infection by Fusarium sambucinum. Funct. Plant Biol. 2012, 39, 236–245. [Google Scholar] [CrossRef]

| Genus | Shape | Color | Size (µm) | Key Morphological Features |
|---|---|---|---|---|
| Rhizophagus sp. | Globose, subglobose | Pale yellow | 40–80 | In cluster, smooth surface |
| Funneliformis sp. | Globose, ellipsoidal | Light brown | 50–90 | Thick walls, subtending hypha |
| Sclerocystis sp. | Aggregated clusters | Pale to dark brown | 40–70 | Smooth wall |
| Scutellospora sp. | Ellipsoidal, irregular | Brownish-orange | 80–120 | Hyphal connections |
| Acaulospora sp. | Globose | Dark yellow | 70–100 | Spore formation directly on the hypha |
| Treatment | Number of Seedlings Tested | Number of Seedlings with Foa Isolated | Percentage of Infection (%) |
|---|---|---|---|
| C | 10 | 0 | 0% |
| Foa | 10 | 10 | 100% |
| AMF | 10 | 0 | 0% |
| AMF + Foa | 10 | 4 | 40% |
Disclaimer/Publisher’s Note: The statements, opinions and data contained in all publications are solely those of the individual author(s) and contributor(s) and not of MDPI and/or the editor(s). MDPI and/or the editor(s) disclaim responsibility for any injury to people or property resulting from any ideas, methods, instructions or products referred to in the content. |
© 2025 by the authors. Licensee MDPI, Basel, Switzerland. This article is an open access article distributed under the terms and conditions of the Creative Commons Attribution (CC BY) license (https://creativecommons.org/licenses/by/4.0/).
Share and Cite
Gagou, E.; Bouchentouf, H.; Chakroune, K.; Abbas, M.; Lamkami, T.; El Jaziri, M.; Hakkou, A. Indigenous Arbuscular Mycorrhizal Fungi Consortium Enhances Growth and Protects Boufeggous Gharas Date Palm Against Fusarium oxysporum f. sp. albedinis Infection in Figuig Oasis (Morocco). Int. J. Plant Biol. 2025, 16, 20. https://doi.org/10.3390/ijpb16010020
Gagou E, Bouchentouf H, Chakroune K, Abbas M, Lamkami T, El Jaziri M, Hakkou A. Indigenous Arbuscular Mycorrhizal Fungi Consortium Enhances Growth and Protects Boufeggous Gharas Date Palm Against Fusarium oxysporum f. sp. albedinis Infection in Figuig Oasis (Morocco). International Journal of Plant Biology. 2025; 16(1):20. https://doi.org/10.3390/ijpb16010020
Chicago/Turabian StyleGagou, Elmostafa, Halima Bouchentouf, Khadija Chakroune, Mahmoud Abbas, Touria Lamkami, Mondher El Jaziri, and Abdelkader Hakkou. 2025. "Indigenous Arbuscular Mycorrhizal Fungi Consortium Enhances Growth and Protects Boufeggous Gharas Date Palm Against Fusarium oxysporum f. sp. albedinis Infection in Figuig Oasis (Morocco)" International Journal of Plant Biology 16, no. 1: 20. https://doi.org/10.3390/ijpb16010020
APA StyleGagou, E., Bouchentouf, H., Chakroune, K., Abbas, M., Lamkami, T., El Jaziri, M., & Hakkou, A. (2025). Indigenous Arbuscular Mycorrhizal Fungi Consortium Enhances Growth and Protects Boufeggous Gharas Date Palm Against Fusarium oxysporum f. sp. albedinis Infection in Figuig Oasis (Morocco). International Journal of Plant Biology, 16(1), 20. https://doi.org/10.3390/ijpb16010020

